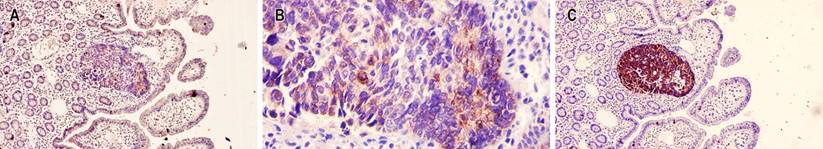

Introduction
Mixed neoplasms were first described in 1924 by Cordier as neoplasms in the gastrointestinal tract with two components: one neuroendocrine and the other adenocarcinoma.1 In 1967, Levine proposed differentiating this neoplastic entity as independent of other neuroendocrine neoplasms.1 Since then, multiple terms have been used for this diagnosis, such as mixed glandular-neuroendocrine compound carcinoma, carcinoid compound adenocarcinoma, mucin-producing carcinoid, and ex-goblet cell carcinoid adenocarcinoma, among others,2 which leads to inconsistencies in the published data on this pathology.3
In 2000, Capella et al. first proposed the standardization of terminology to properly classify mixed neoplasms of the digestive tract.1 In 2010, the World Health Organization (WHO) classified mixed neoplasms of the gastroenteropancreatic tract that contain a neuroendocrine and an exocrine component, and each of them must represent at least 30% of the neoplastic mass.4
The term mixed exocrine-endocrine neoplasia was subsequently replaced by mixed adenoneuroendocrine neoplasia (MANEC), a rare pathology composed of a group of neuroendocrine and exocrine neoplastic cells. However, it is believed that the term MiNEN (mixed neuroendocrine non-neuroendocrine neoplasms), proposed in 2016 by La Rosa et al., better addresses the heterogeneous spectrum of possible combinations between neuroendocrine and non-neuroendocrine elements and the variability of morphologies, which are largely determined by the site of origin.1 In 2019, the WHO established that mixed neuroendocrine neoplasms (TEN) are grouped in the conceptual category of MiNEN.5
Epidemiologically, the incidence of MiNEN is less than 0.01/100,000 cases per year. The rarity of this diagnosis, the limited quality of the published data, the use of inconsistent terminology, and the epidemiology of the treatment of patients with MiNEN remain nonspecific.6,7 Nevertheless, according to the available evidence, this neoplasm is an aggressive element with a high-grade neuroendocrine component in most cases and is associated with poor survival outcomes, close to those of pure neuroendocrine carcinomas.8
The pathogenesis of MiNEN represents a topic of debate between pathologists and clinicians, in which three main theories have been proposed: the first theory suggests that neuroendocrine and non-neuroendocrine components arise independently, synchronously, from distinct precursor cells and fuse subsequently; the second states that the two components derive from a pluripotent progenitor, which acquires a biphenotypic differentiation during carcinogenesis; and a third theory assumes a common monoclonal origin of the two components, but neuroendocrine differentiation occurs in a non-neuroendocrine phenotype after the accumulation of molecular aberrations.9,10 This last theory is based on the fact that non-neuroendocrine neoplasms in the gastrointestinal tract are generally located superficially close to the mucosa, while neuroendocrine neoplasms are located in a deeper area.10
Several studies have attempted to characterize the major genetic and epigenetic aberrations underlying MiNEN, with mutations in tumor-associated genes, including TP53, BRAF, and KRAS, and microsatellite instability emerging as potential triggers for MiNEs. However, to date, they are not clearly established yet.10
Clinical case
This is a 58-year-old woman with a history of hypertension and diabetes mellitus who does not require insulin and who consulted after 20 days of abdominal pain in the left hypochondrium, stabbing type, that expanded to the epigastrium with an intensity 6/10 on the analogous scale of pain associated with generalized jaundiced dye, acolia, choluria, and febrile peaks quantified up to 39 ºC. She underwent some laboratory studies that evidenced hyperbilirubinemia at the expense of direct bilirubin and elevated transaminases. The ultrasound showed hepatic steatosis, the gallbladder without stones inside associated with dilated intra- and extrahepatic bile duct with a common bile duct of 12 mm but did not show the cause of the obstruction. She also underwent a computed tomography (CT) scan and magnetic resonance cholangiopancreatography (Figure 1), which showed dilation of the bile duct secondary to distal choledocholithiasis, and it was decided to take her to endoscopic retrograde cholangiopancreatography (ERCP) to perform the management of obstructive biliary syndrome that had a probable biliary origin. However, a large papilla of neoplastic appearance of 3 centimeters at its greatest diameter was found without canalizing the bile duct. The patient underwent a biopsy and magnetic resonance imaging with double contrast (Figure 2) that reported choledocholithiasis, dilatation of the intra- and extrahepatic bile duct, and dilation of the intrapancreatic duct due to probable periampullary neoplasia.

Figure 1 CT scan with evidence of intra- and extrahepatic bile duct dilation (A) axial section (B), and coronal section. Cholangioresonance shows dilation of the bile duct secondary to choledocholithiasis (C) in the axial section and (D) coronal section. Source: Authors’ archive.

Figure 2 Magnetic resonance imaging contrasted with evidence of dilatation in the intra- and extrahepatic bile duct secondary to periampullary lesion (A) in the axial section and (B) coronal section. Source: Authors’ archive.
The biopsy showed a villous adenoma with low-grade dysplasia. When no clinical-pathological correlation was obtained, the treating service proceeded to perform surgical treatment, and due to intraoperative findings of the bile duct, they decided to perform a biliopancreatic diversion plus pancreatectomy proximal to the open route. When performing the microscopic study, a mixed neoplasm characterized by a neuroendocrine carcinoma, a mucinous adenocarcinoma, and a villous adenoma with low-grade dysplasia were observed, the latter as a possible precursor of mucinous adenocarcinoma (Figure 3).

Figure 3 Microscopic vision with hematoxylin and eosin (H/E) 4x. Mixed adenoneuroendocrine tumor. A. 10x component of neuroendocrine carcinoma. B. 40x component of neuroendocrine carcinoma. C and D. 40x component of mucinous adenocarcinoma. E and F. 40x villous adenoma with low-grade dysplasia. Source: Authors’ archive.
The patient underwent an immunohistochemical study in which they observed a positive marking in neoplastic cells of neuroendocrine carcinoma for chromogranin A, synaptophysin, cytokeratin 7, cytokeratin 17, thyroid transcription factor 1 (TTF-1), a proliferation rate of 98%; negativity for cytokeratin 20, homeobox caudal protein 2 (CDX2), and human epidermal growth factor receptor 2 (HER2) grade 0. Additionally, positivity was shown in mucinous carcinoma cells for cytokeratin 7 and a cell proliferation rate of 90%, and negativity for chromogranin A, synaptophysin, cytokeratin 20, TTF1, CDX2, and HER2 grade 0 (Figures 4 and 5). Microsatellite instability markers are preserved. These findings confirm high-grade neuroendocrine carcinoma associated with a component of mucinous carcinoma.
Figure 4 Immunohistochemical staining in neuroendocrine carcinoma. A. 10x weak immunohistochemical stain for chromogranin A. B. 1100x weak immunohistochemical stain for chromogranin A. C. 10x immunohistochemical stain with strong positivity for chromogranin A. Source: Authors’ archive.

Figure 5 A. 10x positive immunohistochemical stain for cytokeratin 7 in the neuroendocrine adenocarcinoma component. B. 10x cytokeratin 7 positive immunohistochemical stain in the mucinous adenocarcinoma component. C. 10x cell proliferation index of neuroendocrine carcinoma of 98. D. 10x positive cell proliferation rate for most epithelial neoplastic cells. Source: Authors’ archive.
Discussion
Mixed adenoneuroendocrine carcinomas (MiNEN) are biphasic carcinomas consisting of glandular epithelium and neuroendocrine cells. According to what the WHO stated in 2019, its denomination requires that each component represents at least 30% of the constitution of the carcinoma.4,5 It is a rare neoplasm, and the cases in the ampulla of Vater are uncommon. Only nineteen cases have been reported in this location. In the gastrointestinal tract, it is most common in the stomach and colon.11
In the case presented, the definitive diagnosis was made in multiple histological sections of paraffin and complementary immunohistochemical studies that documented the involvement of a mixed adenoneuroendocrine carcinoma of the ampulla of Vater, composed of neuroendocrine carcinoma (40%) and mucinous adenocarcinoma (60%), which confirmed the diagnosis of MiNEN according to the WHO, 2019.5
Symptoms are usually nonspecific and may be generalized. It is frequently abdominal pain, sometimes associated with emetic episodes. In the case presented, the main symptoms were jaundice, acolia, choluria, and febrile peaks. Due to the non-specificity of the obstructive symptoms that occur in these cases, making a clinical-radiological correlation with the pathology is of utmost importance.
This neoplasm located in the ampulla of Váter, as we mentioned previously, is a rare carcinoma, and its behavior is usually aggressive and of poor prognosis, so its treatment is surgical, as proposed in this case. Pancreatoduodenectomy is the most commonly used procedure in these cases, and this type of treatment should be associated with radiotherapy or chemotherapy.6,11










text in 



